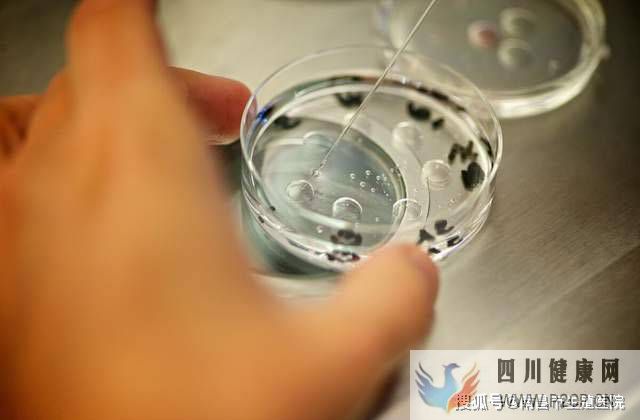
一文读懂，试管婴儿的全过程(第二代试管婴儿怎么做的全过程)(图1)

一文读懂,试管婴儿的全过程(第二代试管婴儿怎么做的全过程)
原标题:一文读懂,试管婴儿的全过程
有时候上帝并不那么公平分配,就像生孩子这回事,对一些人来说特别容易,水到渠成的事情。然而对于某些夫妇来说,却是难如登天,经历的苦楚一言难尽。庆幸医学技术的日益精进,有了试管婴儿这一技术,才有效地解决了不孕不育的难题。
试管婴儿是一种通过体外受精,达到卵子和精子结合的技术。受精成功以后,通过特定的方法把早期胚胎植入女方体内,让它发展成为一个完整的胎儿。
第一步:促排卵
一枚卵子就像一枚葡萄籽,卵泡就像葡萄。正常来说,每个月经周期,在促性腺激素的刺激作用下,排出1颗卵子。
而卵子成功受精并不是百发百中的概率,所以需要从女方身上获得更多的卵子,来提高成功率。也就是我们所说的排卵治疗。而排卵的方法有两种,吃药或打针,提高促性腺激素的水平。
第二步:取卵和取精
提取卵子的过程是在麻醉的状态下完成的,一般来说是感觉不到疼痛的。
具体看参考:试管婴儿取卵是怎么一回事
第三步:体外受精
在特定环境下,促进卵子和精子的结合,形成受精卵。
第四步:胚胎移植
受精卵经过3天左右的培养后,分裂成2-6个细胞后,移植到女方体内,通常移植2-3个胚胎。
第五步:安胎
这一过程很重要,因为不是自然受孕,所以生理周期被破坏了,体内无法正常分泌胎儿成长所必须的孕酮,这时候就需要借助药物作用来进行补充。
第六步:确定怀孕
一些工作就绪了,接下来就只用静静等待好孕了。在移植后的两个礼拜后,就可以用验孕试纸进行检验是否怀孕。如果成功,可喜可贺;如果失败,则需要重新循环到下一个周期。
1. 试管婴儿孕妈需要调整体质
孕妈们在备孕期间需要养成良好的运动习惯,三餐正常进食,不吃冰冷食物,保证营养均衡,保证充足的睡眠,偶尔进行中医调理。(中医调整需要结合各人体制而言)
2. 注意保暖
一些孕妈在秋冬时期开始疗程,所以更加需要主要保暖问题,日常热敷腰背,热水泡脚,用暖宝宝放口袋,多喝温开水。整个人尽量还是保持暖乎乎的状态。
3. 增强信心
心态是做任何事最重要的一点基础,即便你已经失败过几次,即便困难重重,千万不要丢掉信心。在备孕期间需要不断给自己加油打气。保持心情愉悦度,以积极乐观的心态正面面对。
4. 检查
定期的检查必不可少,就像不少孕妈子宫内膜存在息肉的状况,导致迟迟不孕。谨遵医嘱,定时检查按时吃药。
每个宝妈妈都很不容易,不管是自然怀孕,到顺利分娩,还是试管婴儿,对产妇来说都是一种挑战。更重要的是,准妈妈们要有乐观积极的心态,好运总在不经意间降临。返回搜狐,查看更多
责任编辑:





